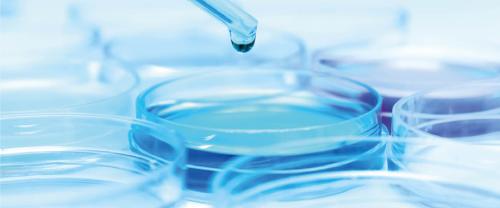
Biosearch Biosearch

La protagonista de la mañana en el mercado continuo español es la empresa de ingredientes y componentes nutricionales Biosearch que sube un 40% en la apertura.
Detrás de esta fuerte subida está la propuesta de compra por parte del grupo Kerry Iberia Taste & Nutrition que ha presentado una oferta para hacerse con el capital de la española por un importe total de 127 millones de euros.
La filial española de la irlandesa Kerry Group ofrece un precio de 2,20 euros por acción en efectivo lo que supone una prima de un 45% respecto al precio de cierre del pasado viernes cuando Biosearch cerró en 1,51 euros.
El director de análisis de Banco Sabadell, Nicolás Fernández, aconseja a los inversores revisar el precio objetivo que maneja el mercado y ver si puede haber o no una mejora.
Escucha su análisis:
Lactalis dice Sí
La propuesta está condicionada a obtener al menos un 50% del capital más una acción y ya tiene parte del camino recorrido porque el Grupo Lactalis Iberia, que es su principal accionista con un 29,5% del capital, ha pactado la venta de sus acciones en la oferta.
En el anuncio de su opa enviado a la Comisión Nacional del Mercado de Valores, los responsables del grupo Kerry han detallado que de salir adelante la operación promoverán la exclusión de Biosearch de la bolsa.
La también cotizada Ebro Foods vendió en 2011 ese porcentaje en Biosearch —antes conocido como Puleva Biotech SA— a la francesa Lactalis, tras lo cual salió de su hasta entonces filial de biotecnología, que debutó en bolsa en 2001.
Kerry comenzó a operar en 1972 en Irlanda hasta convertirse en un actor principal de la industria alimentaria mundial con unos ingresos anuales en torno a los 7.200 millones de euros. De hecho, en su web corporativa se presentan como el líder global en Taste & Nutrition para la industria de alimentos y bebidas.
La empresa cotiza en las bolsas de Dublín y Londres y sus acciones están bajando un 2%.